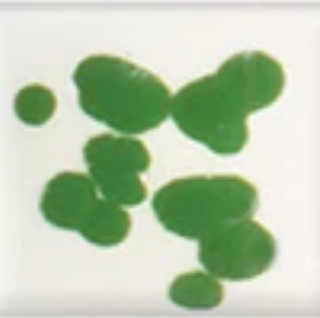
Spectrum Glaze Crystals: (1 Ounce)
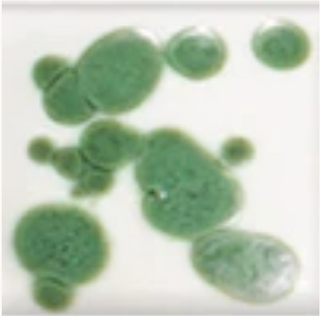
Spectrum Glaze Crystals: (1 Ounce)
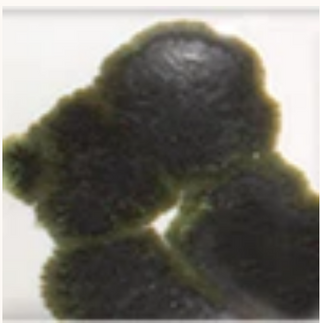
Spectrum Glaze Crystals: (1 Ounce)

Spectrum Glaze crystals
One 1 ounce jar of each of the 12 colors
Spectrum Glaze Crystals are all lead-free and dinnerware safe when fired to a minimum cone 06. These crystals are very versatile and can be used successfully from cone 06 to cone 6.
They can be used with any glaze in this firing range to produce a great variety of different appearances. They can also be intermixed. Many beautiful combinations of two or more colored crystals on your choice of glaze background can be used. Please be aware that, due to varying expansion coefficients, some of these crystals may cause crazing on some glazes, particularly at stoneware temperatures. Please test for suitability in your application.
One method of applying the crystals is to drop them onto the final coat of glaze while the surface is still wet allowing the crystals to stick to the glaze. If the glaze dries out before all the crystals are applied try spraying a little water on the glaze surface to help the crystals stick to it. In this way you can position the crystals where you want them on the piece. Alternatively, you can try sprinkling some of the crystals onto a piece of paper and then dabbing your brush, already loaded with glaze, into the crystals as you are applying the final coat of glaze. However, be aware that these crystals will run a lot when fired up to cone 5 or 6 and should not be applied near the bottom of the piece for stoneware firings. This is not of concern at cone 06 or 05 as they will not move and spread nearly as much at lower temperatures. These crystals can also be mixed into a liquid glaze to be brushed on. However, one of the reasons that we decided not to prepare pre-mixed crystal glazes is that the crystals are large and heavy and tend to settle to the bottom of the container. Therefore, you will need to stir the glaze frequently if you choose to mix the crystals into a glaze.
CUSTOMER REVIEWS - Q&A
Got a question about this product? Ask it here and get a response from our staff and also input from the Sheffield Pottery community!